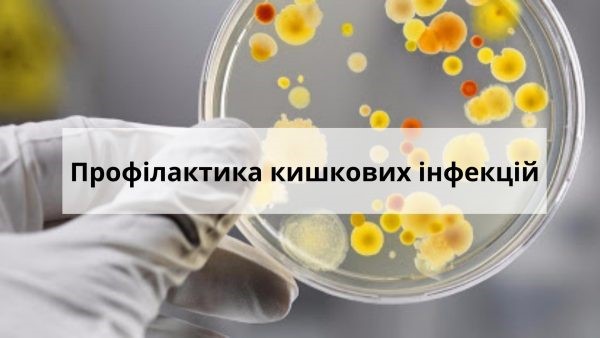

Літо – благодатна тепла пора року: зріють ягоди, фрукти, ми частіше перебуваємо на природі. З настанням тепла люди, та в першу чергу діти, потребують відпочинку та збагачення організму сезонними вітамінами. Але необхідно пам’ятати, що літній сезон – це сприятливий час для поширення гострих кишкових інфекцій, так як саме в цей період збільшується вірогідність споживання немитих фруктів, ягід, вживання в їжу різноманітних салатів, а також купання в непристосованих та забруднених водоймах.
Гострі кишкові інфекції (дизентерія, сальмонельоз, черевний тиф, паратифи А і В, холера, харчові токсикоінфекції та ін.) спричиняються різними збудниками: найпростішими, бактеріями, вірусами тощо.
Існують три шляхи передачі гострих кишкових інфекцій: харчовий, водний і контактно-побутовий.
Основний шлях передачі збудників інфекцій – харчовий, коли зараження відбувається через споживані продукти харчування і приготовлені з них страви, а також овочі та фрукти, забруднені мікроорганізмами і вжиті в їжу без достатньої гігієнічної і термічної обробки.
Водний шлях передачі збудників інфекцій реалізується значно рідше, в основному через забруднення питної води внаслідок аварій на водопровідних та каналізаційних мережах, підтоплення шахтних колодязів під час дощових паводків та повеней.
При контактно-побутовому шляху передачі збудник інфекції може передаватися через забруднені руки, предмети домашнього вжитку (білизна, рушники, посуд, іграшки тощо). Джерелом інфекції також може бути хвора людина з клінічними проявами інфекції або здоровий „носій”. Носії становлять епідеміологічну небезпеку, оскільки вони ведуть активний спосіб життя, при цьому контактують зі здоровими людьми, займаються готуванням страв, будучи хворими працюють на об’єктах громадського харчування, на підприємствах, що займаються виготовленням продуктів харчування. Факторами передачі є м’ясо, яйця, вода, кухонний інвентар, руки, мухи.
Сприйнятливість людей до кишкових захворювань доволі висока. Особливо часто вони спостерігаються у дітей, тому що у малят і захисні сили слабші, і гігієнічні навички ще недостатні.
Щоб вберегти себе від захворювань кишковими інфекціями, необхідно:
- дотримуватися правил особистої гігієни;
- ретельно мити руки з милом перед вживанням їжі, після повернення з вулиці та після кожного відвідування вбиральні;
- мити та тримати у чистоті всі поверхні та кухонні прилади, що використовуються для приготування їжі;
- користуватися індивідуальним посудом;
- запобігати проникненню комах та тварин до приміщень, де відбувається приготування їжі та зберігаються харчові продукти;
- регулярно мити та обдавати окропом дитячий посуд та іграшки;
- окремо готувати і зберігати сирі та готові до вживання харчові продукти (сире м’ясо, птицю, рибу, овочі, фрукти тощо);
- дотримуватись відповідного температурного режиму при зберіганні харчових продуктів (не залишати приготовлені харчові продукти при кімнатній температурі більше, ніж на 2 години);
- використовувати безпечну воду, не пити воду з неперевірених джерел, вживати бутильовану воду, у разі неможливості придбання бутильованої води використовувати охолоджену кип’ячену воду;
- мити та обдавати окропом фрукти і овочі, особливо у разі споживання їх у сирому вигляді;
- не купувати харчові продукти у випадкових осіб або в місцях несанкціонованої торгівлі;
- не вживати та не давати маленьким дітям некип’ячене розливне молоко, сирі яйця тощо;
- не купатися в несанкціонованих для відпочинку водоймах, уникати заковтування води під час купання;
- уникати контактів з особами, які мають ознаки інфекційного захворювання.
При появі симптомів захворювання своєчасно звертайтесь за медичною допомогою. Самолікування може призвести до значних ускладнень. Особливо це стосується дітей раннього віку.
Виконання цих нескладних правил та порад допоможе уникнути захворювання та зберегти Ваше здоров’я та здоров’я Ваших близьких!
Богодухівське районне управління Головного управління
Держпродспоживслужби в Харківській області